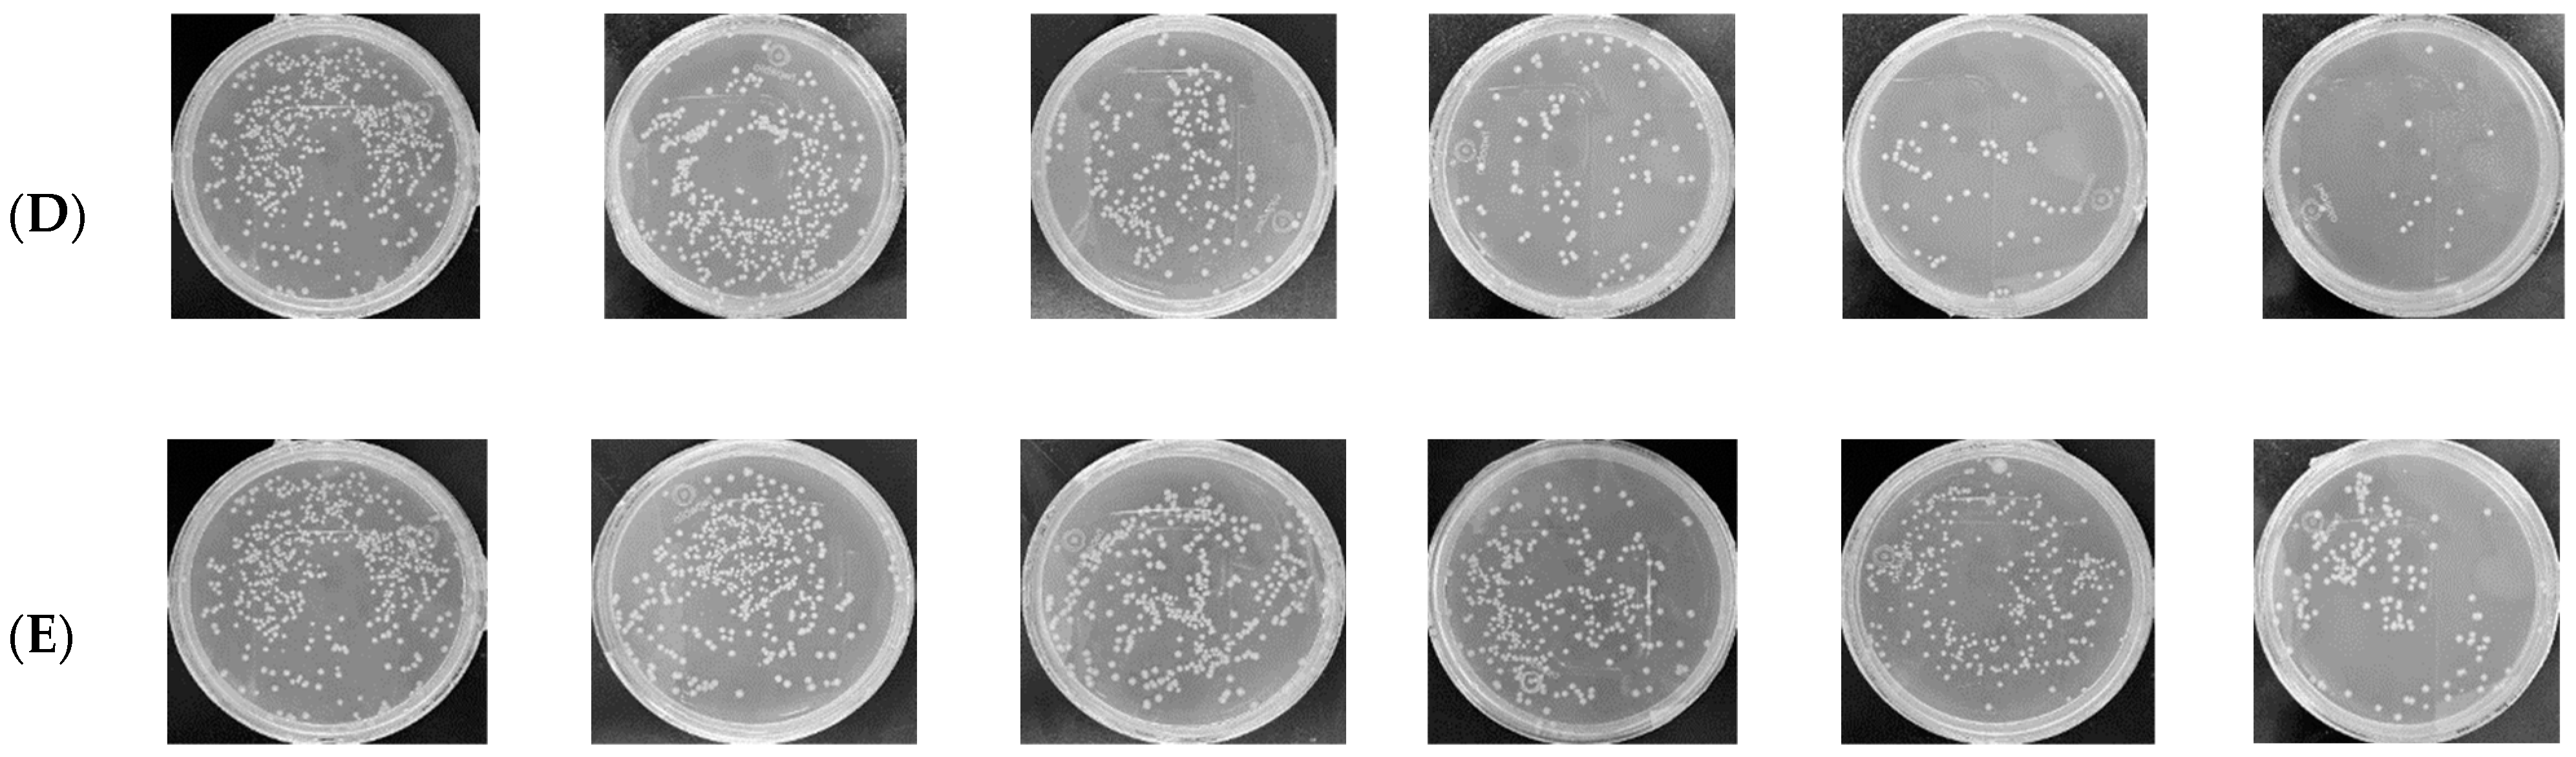
Ijms 25 07288 g004b

Carex meyeriana Kunth Extract Is a Novel Natural Drug against Candida albicans
Abstract
1. Introduction
2. Results
2.1. Chemical Composition of Ethanol Extract from Carex meyeriana Kunth
2.2. The Inhibitory Effect of Carex meyeriana Kunth against C. albicans
2.3. The Anti-Inflammatory of Carex meyeriana Kunth
2.3.1. The Levels of Inflammatory Mediators Are Decrease
2.3.2. Eliminating Inflammation of Vaginal Mucosa Tissue
2.3.3. Metabolites and Metabolic Pathways for Anti-Inflammatory in Vaginal Tissue
- (1)
- Prediction of potential targets in non-targeted metabolomics of vaginal tissue
- (2)
- Non-targeted metabolic pathways in vaginal tissue
2.4. Metabolites and Metabolic Pathway of Carex meyeriana Kunth against C. albicans
2.4.1. Prediction of Potential Targets in Non-Target Metabolomics of C. albicans
2.4.2. Non-Target Metabolic Pathways in C. albicans
3. Discussion
4. Materials
5. Methodology
5.1. Extraction of Carex meyeriana Kunth
5.2. Identification of Ingredients in Carex meyeriana Kunth Extracts
5.3. Vaginitis Rats Were Infected with C. albicans
- (1)
- Pretreatment: After 1 week of adaption, 0.5 mL/100 g estradiol benzoate for veterinary purposes was injected subcutaneously into each rat daily for 2 days. After 6 days, the drug-induced rat estrus model was successfully established, and then the rats were injected every 2 days until the end of the experiment.
- (2)
- Intravaginal inoculation: One day after successfully establishing a drug-induced estrus model in rats, 1.5 × 108 CFU/mL of C. albicans suspension was spread over the vagina mucosa at a dose of 200 μL for each rat. The control group was given an equal amount of sterile water. The procedure was repeated daily for 4 days. The evaluation criteria for a successful infection of C. albicans included visible congestion, edema, and increased secretion of the vulva and vaginal mucosa to the naked eye, as well as fungi (+) in the vaginal secretions.
- (3)
- Drug treatment: All rats were randomly divided into five groups: model group (vaginitis due to C. albicans), control group (2 mL of 0.9% sodium chloride solution), fluconazole (FCZ) group (the C. albicans vaginitis rats were treated with 13.5 mg/kg fluconazole), a high-dose group (the C. albicans vaginitis rats were treated with 8 g/kg of CMK extract), and a low-dose group (the C. albicans vaginitis rats were treated with 2 g/kg of CMK extract), with eight rats in each group. Medication was applied to the vaginal area. Drug treatment continued for 14 consecutive days.
5.4. Numbers of C. albicans Colonies
5.5. Inflammatory Mediators in the Vaginal Tissue
5.6. Vaginal Histopathological Staining
5.7. Metabolomics Analysis
5.8. Statistical Analysis
6. Conclusions
Supplementary Materials
Author Contributions
Funding
Institutional Review Board Statement
Data Availability Statement
Conflicts of Interest
References
- Sobajo, O.A.; Okiki, P.A.; Ade-Ojo, I.P.; Adelegan, O.; Adarabioyo, M.I. Candida albicans virulence genes SAP1 and SAP6 associated with vaginitis among pregnant women attending a Nigerian tertiary hospital. New Microbes New Infect. 2022, 49–50, 101029. [Google Scholar] [CrossRef] [PubMed]
- Yang, Y.; Su, L.; Liu, Y.; Zhuang, X.; Wang, R.; Zhang, Y. Study on the efficacy of rehabilitation new fluid against Candida vaginitis. Mod. Chin. Med. China 2019, 21, 903–908. [Google Scholar]
- Ji, J.; Jiang, Y.; Han, S. In vitro antagonism of C. albicans. World Sci. Technol.-Mod. Tradit. Chin. Med. 2015, 17, 1953–1958. [Google Scholar]
- De Freitas, A.L.D.; Kaplum, V.; Rossi, D.C.P.; da Silva, L.B.R.; Melhem, M.D.S.C.; Taborda, C.P.; de Mello, J.C.P.; Nakamura, C.V.; Ishida, K. Proanthocyanidin polymeric tannins from Stryphnodendron adstringens are effective against Candida spp. isolates and for vaginal candidiasis treatment. J. Ethnopharmacol. 2018, 216, 184–190. [Google Scholar] [CrossRef] [PubMed]
- Li, Z.; Tan, X.; Wang, G.; Chen, C.; Ma, Y.; Astulla, A.; Liu, C.; Yang, J.; He, X. To explore the scientific connotation of traditional Chinese medicine based on “drug-ingredients-target”. Chin. Herb. Med. 2023, 54, 7232–7247. [Google Scholar]
- Qi, J.; Liu, X.; Zhang, Y.; Zhu, G.; Tang, S.; Yu, X.; Su, Y.; Chen, S.; Liang, D.; Chen, G. Adsorption of chloramphenicol from water using Carex meyeriana Kunth-derived hierarchical porous carbon with open channel arrays. Environ. Sci. Pollut. Res. Int. 2023, 30, 31060–31076. [Google Scholar] [CrossRef] [PubMed]
- Su, T. Study on the Antibacterial Active Substances and the Mechanism of Action; Changchun University of Traditional Chinese Medicine: Changchun, China, 2021. [Google Scholar]
- Wang, H. Analysis of the Chemical Composition of Flavonoids and Its Antioxidant and Antibacterial Activity; Jilin University of Chemical Technology: Jilin, China, 2020. [Google Scholar]
- Sousa, Y.V.; Santiago, M.G.; de Souza, B.M.; Keller, K.M.; Oliveira, C.S.; Mendoza, L.; Vilela, R.V.; Goulart, G.A. Itraconazole in human medicine and veterinary practice. J. Mycol. Med. 2024, 34, 101473. [Google Scholar] [CrossRef]
- Fang, J.; Huang, B.; Ding, Z. Efficacy of antifungal drugs in the treatment of oral candidiasis: A Bayesian network meta-analysis. J. Prosthet. Dent. 2021, 125, 257–265. [Google Scholar] [CrossRef]
- Sobel, J. Role of Antifungal Susceptibility tests in the treatment of vulvovaginal candidiasis. Curr. Infect. Dis. Rep. 2023, 25, 29–32. [Google Scholar] [CrossRef]
- Akdağ, D.; Pullukçu, H.; Yamazhan, T.; Metin, D.Y.; Sipahi, O.R.; Ener, B.; Tasbakan, M.I. Fluconazole-Resistant Candida albicans Vaginitis with Cross-Resistance to Azoles: A Case Report. Open Forum Infect. Dis. 2019, 6, 287–288. [Google Scholar] [CrossRef]
- Akdağ, D.; Pullukçu, H.; Yamazhan, T.; Metin, D.Y.; Sipahi, O.R.; Ener, B.; Tasbakan, M.I. Anidulafungin treatment for fluconazole-resistant Candida albicans vaginitis with cross-resistance to azoles: A case report. J. Obs. Gynaecol. 2021, 41, 665–666. [Google Scholar] [CrossRef] [PubMed]
- Zida, A.; Bamba, S.; Yacouba, A.; Ouedraogo-Traore, R.; Guiguemdé, R.T. Anti-Candida albicans natural products, sources of new antifungal drugs: A review. J. Mycol. Med. 2017, 27, 1–19. [Google Scholar] [CrossRef] [PubMed]
- Gao, M.; Wang, H.; Zhu, L. Quercetin assists fluconazole to inhibit biofilm for mations of fluconazole-resistant Candida albicans in in vitro and in vivo antifungal managements of vulvovaginal candidiasis. Cell Physiol. Biochem. 2016, 40, 727–742. [Google Scholar] [CrossRef] [PubMed]
- Cheng, X.; Cheng, Y.; Zhang, N.; Zhao, S.; Cui, H.; Zhou, H. Purification of flavonoids from Carex meyeriana Kunth based on AHP and RSM: Composition analysis, antioxidant, and antimicrobial activity. Ind. Crops Prod. 2020, 157, 112900. [Google Scholar] [CrossRef]
- Bosch, M.; Sánchez-Álvarez, M.; Fajardo, A.; Kapetanovic, R.; Steiner, B.; Dutra, F.; Moreira, L.; López, J.A.; Campo, R.; Marí, M.; et al. Mammalian lipid droplets are innate immune hubs integrating cell metabolism and host defense. Science 2020, 370, eaay8085. [Google Scholar] [CrossRef]
- Bosch, M.; Pol, A. Eukaryotic lipid droplets: Metabolic hubs, and immune first responders. Trends Endocrinol. Metab. 2022, 33, 218–229. [Google Scholar] [CrossRef]
- Tsai, H.C.; Han, M.H. Sphingosine-1-phosphate (S1P) and S1P signaling pathway: Therapeutic targets in autoimmunity and inflammation. Drugs 2016, 76, 1067. [Google Scholar] [CrossRef]
- Kunkel, G.T.; Maceyka, M.; Milstien, S.; Spiegel, S. Targeting the sphingosine-1-phosphate ate axis in cancer, inflammation and beyond. Nat. Rev. Drug Discov. 2013, 12, 688–702. [Google Scholar] [CrossRef]
- Hannun, Y.A.; Obeid, L.M. Sphingolipids and their metabolism in physiology and disease. Nat. Rev. Mol. Cell Biol. 2018, 19, 175–191. [Google Scholar] [CrossRef]
- Hou, L.; Yang, L.; Chang, N.; Zhao, X.; Zhou, X.; Dong, C.; Liu, F.; Yang, L.; Li, L. Macrophage sphingosine 1-phosphate receptor 2 blockade attenuates liver inflammation and fibrogenesis triggered by NLRP3 inflammasome. Front. Immunol. 2020, 11, 1149. [Google Scholar] [CrossRef]
- Park, E.S.; Chol, S.; Shin, B.; Yu, J.; Yu, J.; Hwang, J.M.; Yun, H.; Chung, Y.H.; Choi, J.S.; Choi, Y.; et al. Tumor necrosis factor (TNF) receptor-associated factor (TRAF)-interacting protein (TRIP) negatively regulates the TRAF2 ubiquitin-dependent pathway by suppressing the TRAF2-sphingosine 1-phosphate (S1P) interaction. J. Biol. Chem. 2015, 290, 9660–9673. [Google Scholar] [CrossRef] [PubMed]
- Kitano, M.; Hla, T.; Sekiguchi, M.; Kawahito, Y.; Yoshimura, R.; Miyazawa, K.; Iwasaki, T.; Sano, H. Sphingosine 1-phosphate/sphingosine 1-phosphate receptor 1 signaling in rheumatoid synovium: Regulation of synovial proliferation and inflammatory gene expression. Arthritis Rheum. 2006, 54, 742–753. [Google Scholar] [CrossRef] [PubMed]
- Whitnall, M.H.; Inal, C.E.; Jackson, W.E., III; Miner, V.L.; Villa, V.; Seed, T.M. In vivo Radioprotection by 5-androstenediol: Stimulation of the innate immune system. Radiat. Res. 2001, 156, 283–293. [Google Scholar] [CrossRef] [PubMed]
- Williams, N.C.; O’Neill, L.A.J. A Role for the Krebs cycle intermediate citrate in metabolic reprogramming in innate immunity and inflammation. Front. Immunol. 2018, 9, 317864. [Google Scholar] [CrossRef] [PubMed]
- Pålsson-McDermott, E.M.; O’Neill, L.A.J. Targeting immunometabolism as an anti-inflammatory strategy. Cell Res. 2020, 30, 300–314. [Google Scholar] [CrossRef]
- Jia, L. Effect of Crude Extract of Rostro-Tail Pipa Nail on Autophagy in Rat Aerobic Vaginitis; Dali University: Dali, China, 2021. [Google Scholar]
- Fatahi Dehpahni, M.; Chehri, K.; Azadbakht, M. Effect of Silver Nanoparticles and L-Carnitine Supplement on Mixed Vaginitis Caused by Candida albicans/Staphylococcus aureus in Mouse Models: An Experimental Study. Curr. Microbiol. 2021, 78, 3945–3956. [Google Scholar] [CrossRef]
- Zhang, R. Study on the Anti-Inflammatory Effect and Mechanism of Glucomannan Gel Treatment for Mixed Infectious Vaginitis and Cervicitis in Rats; Shanxi Research Institute of Traditional Chinese Medicine: Taiyuan, China, 2023. [Google Scholar]

| NO. | Components | tR/min | Formula | Calculated Mass (m/z) | Found Mass (m/z) | Error (ppm) | Adducts | Fragment (m/z) |
|---|---|---|---|---|---|---|---|---|
| 1 | Neotigogenin acetate | 7.90 | C12H46O4 | 459.3504 | 458.3396 | 3.5 | +H | 217.1353 |
| 2 | Luteolin | 10.99 | C15H10O6 | 287.0571 | 286.0477 | 2.1 | +H | 117.1326 |
| 3 | Aschantin | 18.94 | C22H24O7 | 401.1601 | 400.1522 | 0.6 | +H | 383.1541, 401.1440 |
| 4 | Echinothiophene | 18.99 | C23H26O10S | 495.1292 | 494.1247 | −2.8 | +H | 475.1083, 493.1315 |
| 5 | Trifolin | 6.98 | C21H20O11 | 447.0937 | 448.1006 | 0.4 | −H | 284.0319 |
| 6 | Orientin | 7.02 | C21H20O11 | 447.0945 | 448.1006 | 1.3 | −H | 285.0397, 297.0378, 299.0555, 327.0535, 357.2607 |
| 7 | Rutin | 7.47 | C27H30O16 | 609.1482 | 610.1534 | 2.1 | −H | 300.1355 |
| 8 | Tracheloside | 8.29 | C27H34O12 | 549.1974 | 550.2050 | −0.4 | −H | 550.2015 |
| 9 | β-Hydroxyisovalerylshikonin | 9.64 | C21H24O7 | 433.1512 | 388.1522 | 0.8 | +HCOO | 225.0732, 252.1370, 338.2455 |
| 10 | Tiliroside | 11.12 | C30H26O13 | 593.1322 | 594.1373 | 2.2 | −H | 255.0274, 284.0324, 285.0409 |
| 11 | Plantamajoside | 11.06 | C29H36O16 | 685.1979 | 640.2003 | −0.7 | +HCOO | 477.1230 |
| 12 | Sinensetin | 12.54 | C20H20O7 | 371.1139 | 372.1201 | 0.3 | −H | 328.0594 |
| 13 | Isodemethylwedelolactone | 14.25 | C15H8O7 | 299.0206 | 300.0270 | 0.9 | −H | 271.0264, 227.0337, 199.0376, 201.0170, 283.0131, 187.0002, 183.0425 |
| 14 | Tricin | 14.93 | C17H14O7 | 329.0673 | 330.0740 | 0.6 | −H | 329.0673, 314.0434, 271.0248, 227.0340, 185.0205, 161.0198 |
| 15 | Isosilybin | 15.17 | C26H24O10 | 495.1297 | 496.1370 | 0.0 | −H | 477.3274 |
| 16 | Wedelolactone | 17.92 | C16H10O7 | 313.036 | 314.0427 | 0.7 | −H | 299.0204 |
| 17 | 9,16-Dioxyhydroxy-10,12,14-triene-18 carbonic acid | 18.47 | C18H30O4 | 309.2059 | 310.2144 | −1.2 | −H | 211.0763 |
| 18 | 6-Gingerol | 20.16 | C17H26O4 | 293.1785 | 294.1831 | 2.6 | −H | 293.1780 |
| 19 | Methyl lucidenate P | 23.92 | C30H44O8 | 531.3007 | 532.3036 | 4.4 | −H | 531.3003 |
| Mode | NO. | tR (min) | Formula | Measured Mass (m/z) | Proposed Identity | CON/MOD | HD/MOD | LD/MOD |
|---|---|---|---|---|---|---|---|---|
| ESI+ | 1 | 0.67 | C6H6O4 | 165.0110 | Sumiki’s acid | ↓ **** | ↓ *** | ↓ * |
| 2 | 0.78 | C8H7NO3 | 166.0426 | 4-Pyridoxolactone | ↓ *** | ↓ ** | ↓ | |
| 3 | 3.52 | C19H39NO3 | 330.3102 | Palmitoyl Serinol | ↓ ** | ↓ * | ↓ ** | |
| 4 | 3.55 | C21H30O2 | 337.2057 | 7-Dehydropregnenolone | ↓ * | ↓ *** | ↓ * | |
| 5 | 3.58 | C21H41NO3 | 356.3294 | Pristanoylglycine | ↑ | ↑ ** | ↑ | |
| 6 | 3.60 | C19H30O2 | 313.2026 | 5-Androstenediol | ↑ ** | ↑ | ↓ | |
| 7 | 3.72 | C4H7O7P | 199.0095 | Dihydroxyacetone Phosphate Acyl Ester | ↓ **** | ↓ | ↑ | |
| 8 | 4.46 | C19H26O2 | 286.4085 | Androst-4-ene-3,17-dione | ↑ | ↑ * | ↑ | |
| 9 | 4.80 | C20H32O6 | 368.2258 | 6,15-Diketo,13,14-dihydro-PGF1a | ↑ | ↓ **** | ↓ | |
| 10 | 6.79 | C26H43NO6 | 466.3181 | Glycocholic acid | ↑ ** | ↓ *** | ↓ * | |
| 11 | 7.36 | C19H32O | 299.2216 | 5a-Androstan-3b-ol | ↑ | ↑ * | ↑ | |
| 12 | 7.39 | C20H34O5 | 354.2460 | Prostaglandin F2a | ↑ **** | ↑ **** | ↑ *** | |
| 13 | 14.24 | C36H71NO3 | 566.5704 | N-Acylsphingosine | ↑ *** | ↑ | ↓ | |
| ESI− | 14 | 0.65 | C3H6O4 | 142.9751 | Glyceric acid | ↑ | ↑ * | ↑ |
| 15 | 0.72 | C6H8O7 | 191.0194 | Citric acid | ↑ ** | ↑ * | ↑ | |
| 16 | 1.30 | C2H2O3 | 72.9931 | Glyoxylic acid | ↓ | ↓ * | ↓ | |
| 17 | 2.82 | C8H16N2O3 | 187.1090 | N6-Acetyl-L-lysine | ↓ | ↓ * | ↓ | |
| 18 | 2.88 | C22H32O3 | 343.2351 | 19(20)-EpDPE | ↓ * | ↓ ** | ↓ | |
| 19 | 2.99 | C22H30O5 | 373.2152 | 11β,20-Dihydroxy-3-oxopregn-4-en-21-oic acid | ↓ | ↓ *** | ↓ | |
| 20 | 3.23 | C22H32O2 | 327.2387 | Docosahexaenoic acid | ↑ ** | ↑ | ↓ | |
| 21 | 3.41 | C6H6O6 | 173.0022 | cis-Aconitic acid | ↓ | ↓ * | ↓ * | |
| 22 | 3.67 | C25H34O8 | 461.2159 | 6-Dehydrotestosterone glucuronide | ↑ | ↑ **** | ↓ | |
| 23 | 3.72 | C19H38O2 | 343.2713 | Nonadecanoic acid | ↓ ** | ↓ *** | ↓ | |
| 24 | 4.13 | C21H34O4 | 349.2259 | 5a-Tetrahydrocorticosterone | ↓ * | ↓ | ↓ * | |
| 25 | 4.49 | C24H38O5 | 405.2675 | 7-Ketodeoxycholic acid | ↓ *** | ↓ *** | ↓ | |
| 26 | 6.08 | C18H35NO3 | 312.2468 | Palmitoylglycine | ↓ | ↓ ** | ↓ |
| Mode | NO. | tR (min) | Formula | Measured Mass (m/z) | Proposed Identity | CMK/CON |
|---|---|---|---|---|---|---|
| ESI+ | 1 | 0.43 | C21H28O5 | 361.1924 | Aldosterone | ↓ ** |
| 2 | 0.56 | C14H23N6O3S | 378.1431 | S-Adenosylmethioninamine | ↑ * | |
| 3 | 0.97 | C3H7NO2S | 121.1586 | L-Cysteine | ↓ * | |
| 4 | 1.16 | C13H22N4O8S2 | 449.0710 | Cysteineglutathione disulfide | ↓ **** | |
| 5 | 1.68 | C19H28O3 | 327.2012 | 16-Oxoandrostenediol | ↓ ** | |
| 6 | 2.60 | C24H40O7S | 472.2553 | Chenodeoxycholic acid 3-sulfate | ↑ *** | |
| 7 | 4.01 | C19H30O3 | 329.2136 | 5-Androstenetriol | ↓ **** | |
| 8 | 5.53 | C22H45NO | 340.3487 | Docosanamide | ↓ * | |
| 9 | 7.35 | H2O3S2 | 114.1445 | Thiosulfate | ↑ ** | |
| 10 | 8.28 | C10H14N5O10PS | 450.0111 | Adenosine phosphosulfate | ↑ * | |
| 11 | 8.90 | C7H14N2O4S | 223.0655 | Allocystathionine | ↓ *** | |
| 12 | 9.69 | C7H15N2O8P | 286.0493 | Glycineamide ribotide | ↓ **** | |
| 13 | 10.13 | C26H45NO6S | 499.3147 | Taurochenodesoxycholic acid | ↓ *** | |
| 14 | 12.20 | C17H33NO4 | 316.2619 | Decanoylcarnitine | ↓ *** | |
| 15 | 12.40 | C8H17NOS2 | 230.0593 | Dihydrolipoamide | ↓ * | |
| ESI− | 16 | 0.95 | C14H11Cl2NO3 | 356.0077 | 4′-Hydroxydiclofenac | ↑ * |
| 17 | 6.52 | C26H32O14 | 613.1773 | Phloretin xylosyl-galactoside | ↑ **** | |
| 18 | 11.33 | C10H12N4O6 | 329.0666 | Xanthosine | ↑ **** | |
| 19 | 12.54 | C24H38O4 | 390.2764 | 9′-Carboxy-alpha-chromanol | ↓ * | |
| 20 | 12.65 | C11H14O4 | 209.0820 | 3,4-Dihydroxyphenylvaleric acid | ↓ **** | |
| 21 | 12.94 | C10H13N4O8P | 348.2062 | Inosinic acid | ↑ ** | |
| 22 | 13.48 | C15H22O2 | 279.1617 | Valerenic acid | ↓ **** | |
| 23 | 13.99 | C7H12N2O6 | 265.0702 | L-β-aspartyl-L-serine | ↑ ** |
Disclaimer/Publisher’s Note: The statements, opinions and data contained in all publications are solely those of the individual author(s) and contributor(s) and not of MDPI and/or the editor(s). MDPI and/or the editor(s) disclaim responsibility for any injury to people or property resulting from any ideas, methods, instructions or products referred to in the content. |
© 2024 by the authors. Licensee MDPI, Basel, Switzerland. This article is an open access article distributed under the terms and conditions of the Creative Commons Attribution (CC BY) license (https://creativecommons.org/licenses/by/4.0/).
Share and Cite
Du, P.; Liu, B.; Wang, X.; Zheng, Z.; Liu, S.; Guan, S.; Hou, Z. Carex meyeriana Kunth Extract Is a Novel Natural Drug against Candida albicans. Int. J. Mol. Sci. 2024, 25, 7288. https://doi.org/10.3390/ijms25137288
Du P, Liu B, Wang X, Zheng Z, Liu S, Guan S, Hou Z. Carex meyeriana Kunth Extract Is a Novel Natural Drug against Candida albicans. International Journal of Molecular Sciences. 2024; 25(13):7288. https://doi.org/10.3390/ijms25137288
Chicago/Turabian StyleDu, Panpan, Bingyan Liu, Xueting Wang, Zhong Zheng, Shu Liu, Songlei Guan, and Zong Hou. 2024. "Carex meyeriana Kunth Extract Is a Novel Natural Drug against Candida albicans" International Journal of Molecular Sciences 25, no. 13: 7288. https://doi.org/10.3390/ijms25137288
APA StyleDu, P., Liu, B., Wang, X., Zheng, Z., Liu, S., Guan, S., & Hou, Z. (2024). Carex meyeriana Kunth Extract Is a Novel Natural Drug against Candida albicans. International Journal of Molecular Sciences, 25(13), 7288. https://doi.org/10.3390/ijms25137288

